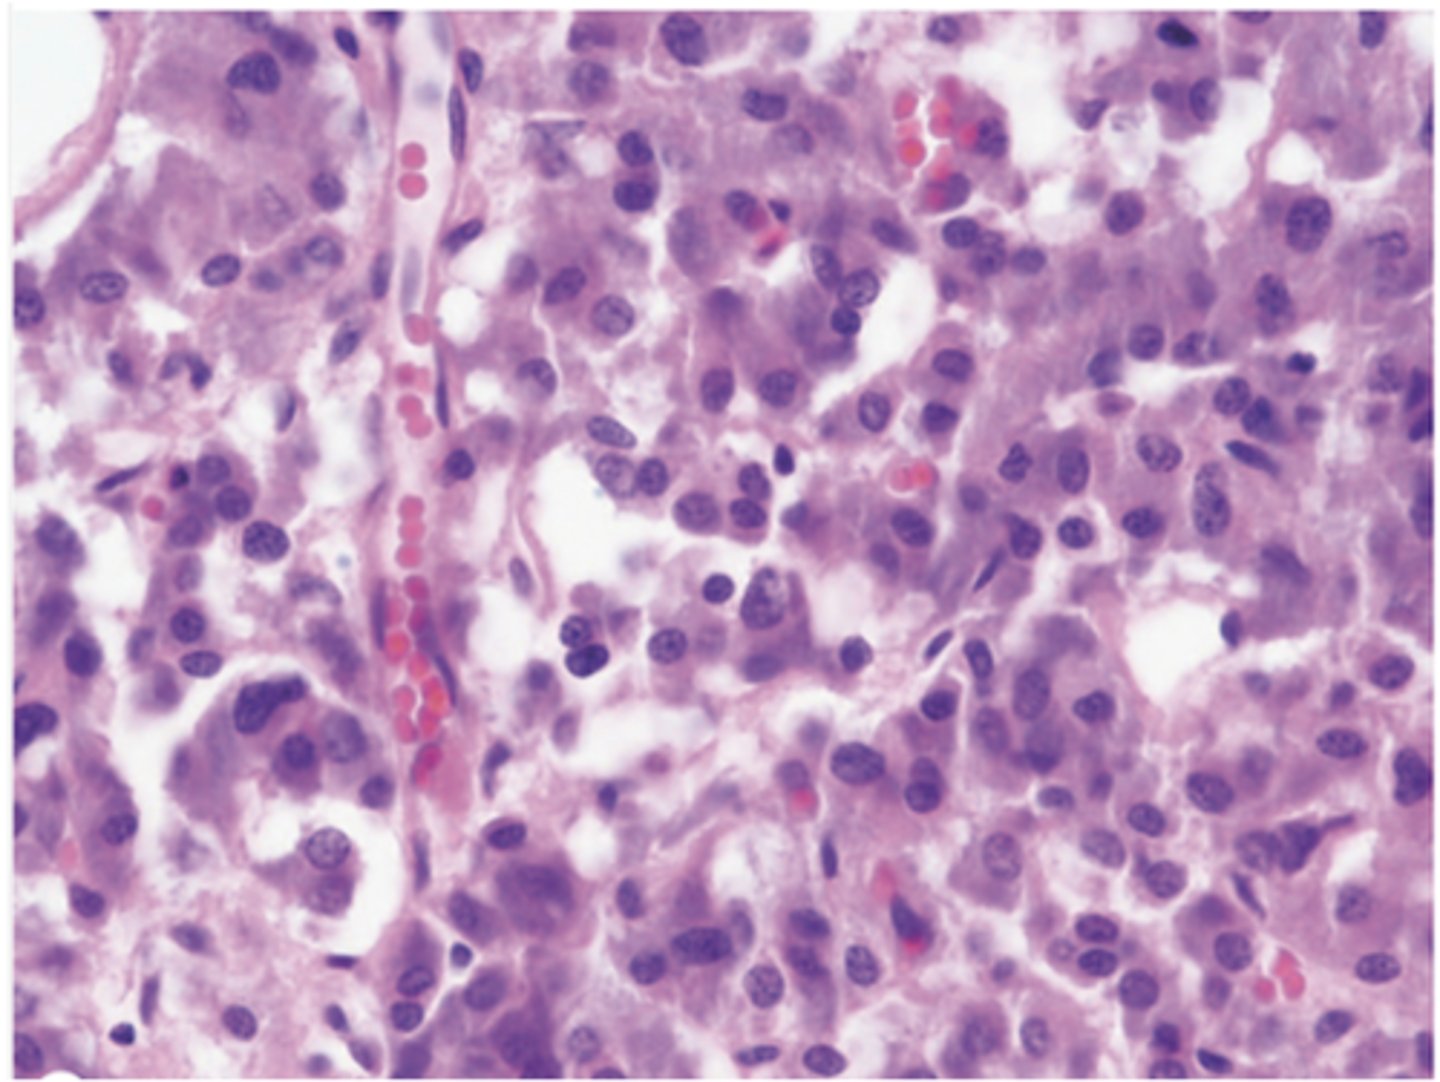

1/109
Looks like no tags are added yet.
Name | Mastery | Learn | Test | Matching | Spaced | Call with Kai |
|---|
No analytics yet
Send a link to your students to track their progress
What are the main functions of the endocrine system?
Homeostasis, growth, and development
What are the components of the endocrine system?
- Organs
- Clusters or cords of cell epithelial origin
- Ductless
- Hormones released to neighboring vascularized compartment

Which organs have endocrine functions? (5)
- Heart
- Thymus
- Kidneys
- Gut
- Gonads

How do hydrophilic hormones act on target cells?
They act on receptors located on the cell surface.

How do hydrophilic hormones travel in the bloodstream?
They travel dissolved in plasma.
What are examples of hydrophilic hormones? (4)
• Proteins
• Glycoproteins
• Peptides
• Modified amino acids

How do lipophilic hormones act on target cells?
They act on cytoplasmic receptors.

How do lipophilic hormones travel in the bloodstream?
They travel bound to transport proteins.

What are examples of lipophilic hormones?
• Steroid-based hormones
• Thyroid hormones

What is the embryologic origin of the pituitary gland?
It has a dual origin: a neural component and an oral component.

What does the neural component of the pituitary gland develop from?
the neurohypophyseal bud, which grows down from the future diencephalon and remains attached to the brain.

What does the oral component of the pituitary gland develop from?
An outpocketing of oral ectoderm that grows cranially to form the hypophyseal (Rathke) pouch.

What happens to the base of the hypophyseal (Rathke) pouch in the oral component during development?
It constricts and separates from the pharynx.

What is the hypothalamic-hypophyseal tract?
A bundle of axons of neurosecretory cells from the supraoptic and paraventricular nuclei of the hypothalamus*** that connects the nuclei to the neurohypophysis.

What is the function of the hypothalamic-hypophyseal tract?
It transports hormones from the hypothalamic nuclei to the neurohypophysis via axonal transport.

Where are hormones stored in the hypothalamic-hypophyseal tract?
In axon dilations called Herring bodies located in the neurohypophysis.
What are the main parts of the neurohypophysis (posterior pituitary)? (2)
1. The infundibular stalk (smaller, fibrous component)
2. pars nervosa (larger).
Does the Pars Nervosa of the Neurohypophysis contain hormone-synthesizing cells?
No, it does not contain hormone-synthesizing cells; it consists of neural tissue.
What type of axons are found in the Pars nervosa of the neurohypophysis?
Unmyelinated axons of secretory neurons whose cell bodies are located in the hypothalamus.
What type of capillaries are present in the neurohypophysis?****
Fenestrated capillaries

What are pituicytes, and what is their function?
Pituicytes are branched glial cells, the most abundant cell type in the neurohypophysis, similar to astrocytes

What are neurosecretory (Herring) bodies in the Neuropophysis?
- Axonal dilations containing membrane-enclosed granules that store hormones (either oxytocin or ADH)
- They appear eosinophilic under the microscope.
What are the hormones of the posterior pituitary? What are their functions? (2)
1. Vasopressin (ADH): Increases water permeability of renal collecting ducts
2. Oxytocin: Stimulates contraction of mammary gland myoepithelial cells and Uterine SM

Where does the hypothalamic-hypophyseal portal system originate*** and where is it drained?
It originates from the internal carotid artery and is drained by the hypophyseal vein.

What are the two hypophyseal arterial groups?
1. superior hypophyseal arteries
2. Inferior hypophyseal arteries

What do the superior hypophyseal arteries form in the adenohypophysis?
They form the primary capillary plexus (fenestrated capillaries), which then rejoin to form hypophyseal portal veins, branching again to form the secondary capillary plexus in the adenohypophysis.

How do capillaries in the hypothalamic-hypophyseal portal system eventually drain?
he capillaries join to form the hypophyseal veins, which drain the adenohypophysis.
What is the largest part of the anterior pituitary?
The pars distalis, which makes up about 75% of the anterior pituitary.
What surrounds the pars distalis of the adenohypophysis?
A thin fibrous capsule.
What type of blood vessels are present in the anterior pituitary?
Fenestrated capillaries and some sinusoids, allowing efficient hormone exchange.
What type of connective tissue supports the anterior pituitary?
Reticular connective tissue.

What are the two main groups of cells in the anterior pituitary? (2)
1. Chromophils (acidophils & basophils)
2. Chromophobes

What are chromophils in the pars distalis?
Secretory cells that synthesize and store hormones in cytoplasmic granules.

What cellular features do chromophils have?
A well-developed Golgi complex, euchromatic nucleus, and cytoplasm filled with secretory granules.

What are the two groups of chromophil cells in the anterior pituitary? (2)
Basophils and acidophils.
What are the acidophil cells of the pars distalis? (2)
1. Somatotrophs (produce growth hormone, ~50% of pars distalis) and 2. 2. lactotrophs (produce prolactin).
What are the basophil cells of the pars distalis? (3)
1. Corticotrophs (produce ACTH)
2. Gonadotrophs (produce FSH and LH)
3. Thyrotrophs (produce TSH, least abundant cells).

How do chromophobes stain and what is their granule content?
They stain weakly and have few or no secretory granules.

What types of cells are included in chromophobes?
Heterogeneous group:
- Stem cells
- undifferentiated progenitor cells
- degranulated cells.
What are the cells of the pars distalis (5)
1. Somatotrophs
2. Lacotrophs
3. Gonadotrophs
4. Thyrotrophs
5. Corticotrophs

What is the shape and location of the pars tuberalis?
Funnel-shaped, surrounding the infundibulum of the neurohypophysis.

What is the main cell type in the pars tuberalis?
Gonadotrophs

Where is the pars intermedia located?
A narrow region between the pars distalis and pars nervosa.

What are the main cell types in the pars intermedia?
1. Basophils (corticotrophs): produce MSH***
2. Chromophobes
3. Colloid-filled cyst: remnants of the Rethke pouch

What are the adrenal glands and where are they located?
Paired, retroperitoneal organs located above the kidneys
What is the stroma of the adrenal glands composed of?
- Thick capsule of dense connective tissue
- Trabecuale of CT carrying blood vessels
- Reticular supporting CT

How is the parenchyma of the adrenal glands organized?
- Cells grouped in cords***
Two regions:
- Adrenal cortex
- Adrenal medulla

What is the embryologic origin of the adrenal cortex?
Mesodermal origin, located between the capsule and medulla.

What is the embryologic origin of the adrenal medulla?
Neural crest origin, considered a modified sympathetic ganglion.

What is a key vascular feature of the adrenal medulla?
Large central adrenomedullary veins.

What is the adrenal cortex, and where is it located?
- The mesodermal origin
- The peripheral region
- between the capsule and medulla, is responsible for synthesizing steroid-based hormones.

What are the three concentric zones*** of the adrenal cortex and their main hormones?
1. Zona glomerulosa – mineralocorticoids
2. Zona fasciculate – glucocorticoids
3. Zona reticularis – androgens
What are the light microscope features of adrenal cortex cells?
Acidophilic cytoplasm, lipid droplets, and euchromatic central nucleus.
What are the electron microscope features of adrenal cortex cells?
Profuse smooth ER (SER), spherical mitochondria with tubular/vesicular cristae, Golgi apparatus, some rough ER (RER), and lysosomes.

Where is the zona glomerulosa located, and what proportion of the adrenal cortex does it make up?
Just below the capsule, making up about 15% of the adrenal cortex.

What is the cellular arrangement and shape in the zona glomerulosa?
Closely packed, rounded or arched cords of columnar or pyramidal cells.

What hormones are secreted by the zona glomerulosa?
Mineralocorticoids, mainly aldosterone.

What type of blood supply is abundant in the zona glomerulosa?
Capillaries, part of the subcapsular arterial plexus.

Where is the zona fasciculata located and what proportion of the adrenal cortex does it make up?
Middle zone (between zona glomerulosa and zona reticularis), making up 65–80% of the cortex.

What are the cell characteristics of the zona fasciculata?
Large polyhedral cells with abundant vacuoles, arranged in long cords one or two cells thick.

What hormones are secreted by the zona fasciculata?
Glucocorticoids (mainly cortisol) and small amounts of weak androgens.

What type of capillaries are found in the zona fasciculata?
Fenestrated capillaries located between the cords.

Where is the zona reticularis located and what proportion of the adrenal cortex does it make up?
Innermost cortical zone, making up about 10% of the cortex.

What are the cellular characteristics of the zona reticularis?
Small cells, intensely stained, less lipid, with abundant lipofuscin pigment.

What hormones are secreted by the zona reticularis?
Some cortisol, but mainly weak androgens (DHEA), which can be converted to testosterone in both males and females.

How are the cells arranged in the zona reticularis and what is the vascular pattern?
Irregular cords with wide capillaries.

What are the main characteristics of adrenal medulla cells?
Large, pale-staining cells arranged in cords or clumps.
What type of supporting tissue is found in the adrenal medulla?
Reticular connective tissue

What is the vascular pattern in the adrenal medulla?
Profuse sinusoids located between the cell cords.

What specialized cells are present in the adrenal medulla?
Ganglion cells.
What are chromaffin cells and their origin?
Secrete epinephrine (E) and norepinephrine (NE); originate from the neural crest and are considered modified sympathetic ganglion cells.
How are chromaffin cells structurally different from typical neurons?
They lack axons and dendrites and are specialized for secretion.
What are the light microscope features of chromaffin cells?
Weakly basophilic cytoplasm with a granular appearance.
What are the electron microscope features of chromaffin cells?
Profiles of RER, well-developed Golgi apparatus, and secretory granules with varying electron density.

What are pancreatic (Langerhans) islets?
Compact or spherical masses of endocrine cells are embedded within the exocrine pancreatic acini.

How many pancreatic islets are in the human pancreas?
More than one million, with the number decreasing from the tail to the head of the pancreas.

What surrounds the pancreatic islets?
A thin reticular capsule.

How are the cells in the pancreatic islets?
•Polygonal or rounded
•More lightly-stained than surrounding acinar cells
•Arranged in cords***
•Interspersed capillaries
How do pancreatic islet cells appear on H&E staining?
All look similar, some intensively basophilic, with subtle size differences and fine cytoplasmic granules.
Which staining methods improve the differentiation of pancreatic islet cells?
Aldehyde fuchsin improves differentiation, but immunohistochemistry provides ideal differentiation.

What hormone do α cells secrete and where are they located in the islet?
Glucagon, located peripherally in the islet.

What hormone do β cells secrete and where are they located in the islet?
Insulin, located centrally, and they are the most abundant islet cells.

What hormone do δ cells secrete and how abundant are they?
Somatostatin, scattered and much less abundant than α and β cells.

What hormone do PP cells secrete and where are they most commonly found?
Pancreatic polypeptide, few in number, more common in the islets of the pancreatic head.

What are enterochromaffin cells in the pancreas?
Cells that secrete hormones affecting the digestive system, found in very few numbers in islets, pancreatic acini, and ducts.

Where is the thyroid gland located and how is it structured?
Anterior and inferior to the larynx, with two lobes connected by the isthmus.

What is the embryologic origin of the thyroid gland?
Endoderm of the foregut.

What hormones are secreted by the thyroid gland? (3)
Thyroxine (T4), Tri-iodothyronine (T3), and Calcitonin.

What forms the stroma of the thyroid gland?
A capsule of fibrous connective tissue with septa extending into the parenchyma.

What is the function of the septa in the thyroid stroma?
They divide the thyroid into lobules and carry blood vessels, lymphatic vessels, and nerves.

What connective tissue supports the thyroid follicles?
Reticular connective tissue.

What type of capillaries are abundant in the thyroid stroma?
Fenestrated capillaries.

What is the basic structural unit of the thyroid parenchyma?
Millions of round, densely packed thyroid follicles.

What type of epithelium lines thyroid follicles?
Simple epithelium.

What is found in the central lumen of thyroid follicles?
Stored secretory product (colloid), which is rich in thyroglobulin, the precursor of T3 and T4.

What is the shape of thyroid follicular cells under a light microscope?
Squamous to low columnar epithelial cells, with shape and follicle size depending on cell activity.

What are the cytoplasmic features of follicular cells?
Slightly basophilic basal cytoplasm, containing lipid droplets and PAS-positive droplets.

What are the nuclear features of follicular cells?
Spherical nuclei with one or two prominent nucleoli.
Where are C (parafollicular) cells located in the thyroid?
Inside the basal lamina of follicular epithelium or in isolated clusters between follicles.

How many parathyroid glands are there and where are they located?
Four ovoid masses located on the posterior aspect of the thyroid gland